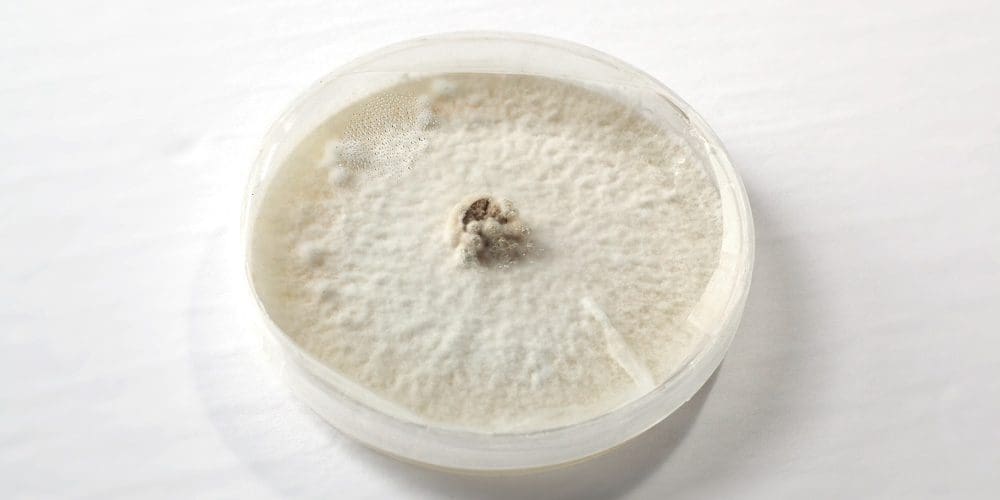

Magic mycelium: How mushroom leather could help clean up the textile industry
By Anita Elash | February 10, 2023

Stephanie Lipp, co-founder of MycoFutures North Atlantic, is developing a mushroom-based fabric that looks and feels like leather.
Stephanie Lipp grew up hating mushrooms. But in the last three years, they’ve taken over her life, her career and a large portion of the Newfoundland home she shares with her partner, Leo Gillis.
Ground zero is in the dining room, where Gillis is experimenting with mycelium — the root system from which mushrooms grow. An assortment of Petri dishes, test tubes and syringes sit next to a large HEPA filter. Mycelium cultures — at various stages of development — are growing in stubby Mason jars. Sterilizing equipment and other paraphernalia are carefully arranged on IKEA bookshelves.
“It’s literally just everywhere,” Lipp says during a personalized Zoom tour. “It’s just seeped everywhere in the house.”
The process of creating the alternative leather starts in a sterilized Petri dish containing agar, a nutrient-rich growth medium and a few mycelium cells.
The process of creating the alternative leather starts in a sterilized Petri dish containing agar, a nutrient-rich growth medium and a few mycelium cells.
This fungi takeover is all part of a bold endeavour to turn mycelium into mushroom leather, one of a new generation of bio-based materials that aims to reduce the environmental damage caused by textile production and the fashion industry. Lipp and Gillis have been at it for just a year and are still finessing their product. If they succeed, their startup, MycoFutures North Atlantic, will join a nascent movement to dramatically reduce the consumption of leather and “vegan” substitutes. Lipp sees “huge potential” for mushrooms to reduce fashion’s impact on the planet. “It won’t solve all our problems,” she says. “But having an option, where conscious consumers can make a good choice, is really important.”
Targeting the worst of the worst
By focusing on an alternative to animal leather, Lipp and Gillis are targeting one of the worst offenders in an industry that’s especially damaging to the planet. In 2019, the fashion industry produced 10 percent of global carbon emissions, and it’s projected that figure could double by 2030. In terms of textiles, bovine leather has been identified as a top offender, due to the deforestation and the GHG emissions associated with raising cattle. Producing “vegan” leather causes fewer emissions, according to some reports, but most of it is made from polyvinyl chloride plastic, a petroleum product.
Mycelium offers a promising alternative. It grows quickly on sawdust, which is compostable, and does not require energy-intensive inputs, such as high heat or intense light. Mycelium sheets can be grown to the exact size needed to produce an item, eliminating waste. The finished product is also biodegradable, making it a prime example of circular production, Lipp says.
 It takes about six weeks for the mycelium to grow in to a sheet of pliable material.
It takes about six weeks for the mycelium to grow in to a sheet of pliable material.
Mycelium stands out among other new plant-based leathers for its structure — a tangled mass of roots, which closely resembles the structure of animal leather. That gives it natural strength without the use of binders such as adhesive.
Lipp describes herself as “an accidental environmentalist.” After a career in photography and graphic design, Lipp became hooked on fungi after moving to Bonavista from Mississauga to set up a gourmet mushroom farm with Gillis in 2019. The couple was “looking for an adventure,” says Lipp, and through online searches, they discovered that Bonavista was a growing community that offered low real estate prices and good business opportunities. Neither has any formal training in science or bioengineering, but as they learned to produce mushrooms in their basement, they were struck by the role that mycelium and other fungi play in maintaining a healthy ecosystem.
Fungi form the tangled underground base that supports most plant life. These buried networks of mycorrhizal fungi absorb carbon, defend plants from disease and supply up to 80 percent of a plant’s nutrients.
“The more you learn about fungi as an organism and how it fits into the environment, and then when you really start looking at nature, you’re like, oh, man, we are really doing a bad job at protecting it,” she says.
They established MycoFutures last year as a way to expand their mushroom operation beyond their community. “What we found exciting about the idea of making a material is that we could figure out a big scientific process and a sustainability challenge,” she said. MycoFutures is one of 10 ventures in the RBC Women in Cleantech Accelerator, a program that aims to help women advance their breakthrough ideas into market-ready cleantech products.
The transition from growing mushrooms to eat to growing them to produce a fabric has involved a lot of trial and error. From a technical perspective, mushrooms and mycelium both require a sterile environment and high humidity. The difference is there’s just one “recipe” for growing mushrooms, which involves precise amounts of humidity and light, but many variations for growing mycelium, each with a slightly different result.
To come up with one that works for him, Gillis read scientific papers, connected with other growers and conducted his own experiments. After dozens of experiments, Gillis has settled on a technique that produces the results he’s looking for. It now takes about six weeks to take it from a Petri dish to a sheet of pliable material that resembles a slightly bumpy pita.
 Mycelium sheets can be grown to the exact sizes needed, which helps cut down on waste.
Mycelium sheets can be grown to the exact sizes needed, which helps cut down on waste.
Several high-end fashion brands have already started using mushroom leather, including Balenciaga, Stella McCartney and Lululemon. However, the biggest manufacturers — Bolt Threads and MycoWorks — are still operating at a small scale, which has kept prices out of reach for most consumers. (Stella McCartney’s mushroom leather bag will set you back about $3,300.)
Warren Mabee, a bio economy expert at Queen’s University, predicts it will be difficult to ramp up mushroom leather to an industrial scale. “This, to me, is a very boutique application,” he says.
He notes the leather has to grow on a flat surface, which may make large-scale production too space-intensive to be sustainable. However, he said that even if companies never produce the material on an industrial scale, mushroom and other plant-based leathers have a lot of potential to reduce fashion’s environmental impact. “It’s this kind of creative thinking that will help society move past the challenges we have,” he says.
Produced at a smaller scale, mushroom leather might not be a great choice for upholstery but could still play a role in making accessories, such as purses and shoes, more sustainable.
As CEO, Lipp is gearing up to raise funding to help expand the company — so that Gillis could move the lab out of their dining room into a separate facility and hire a biochemist and a processing engineer. Their goal is to produce 200 square metre samples to send to brands that are interested in experimenting with the fabric.
The company is also working to improve the sustainability of mushroom leather. Most of the mushroom leather that’s currently on the market contains up to 50 per cent plastic (it’s added for water-resistance and to keep the leather pliable). Lipp says MycoFutures is looking for an alternative and is experimenting with non-toxic leather tanning techniques that could replace petroleum products.
One year in, Lipp’s fascination with mycelium grows every day. “I never really considered myself a scientist but now I’m never tired of it,” she said. “I just always want to learn more.”
MaRS believes “innovation” means advancing Canadian technology for the benefit of all people. Join our mission.
Photos courtesy of MycoFutures North Atlantic
 Anita Elash
Anita Elash